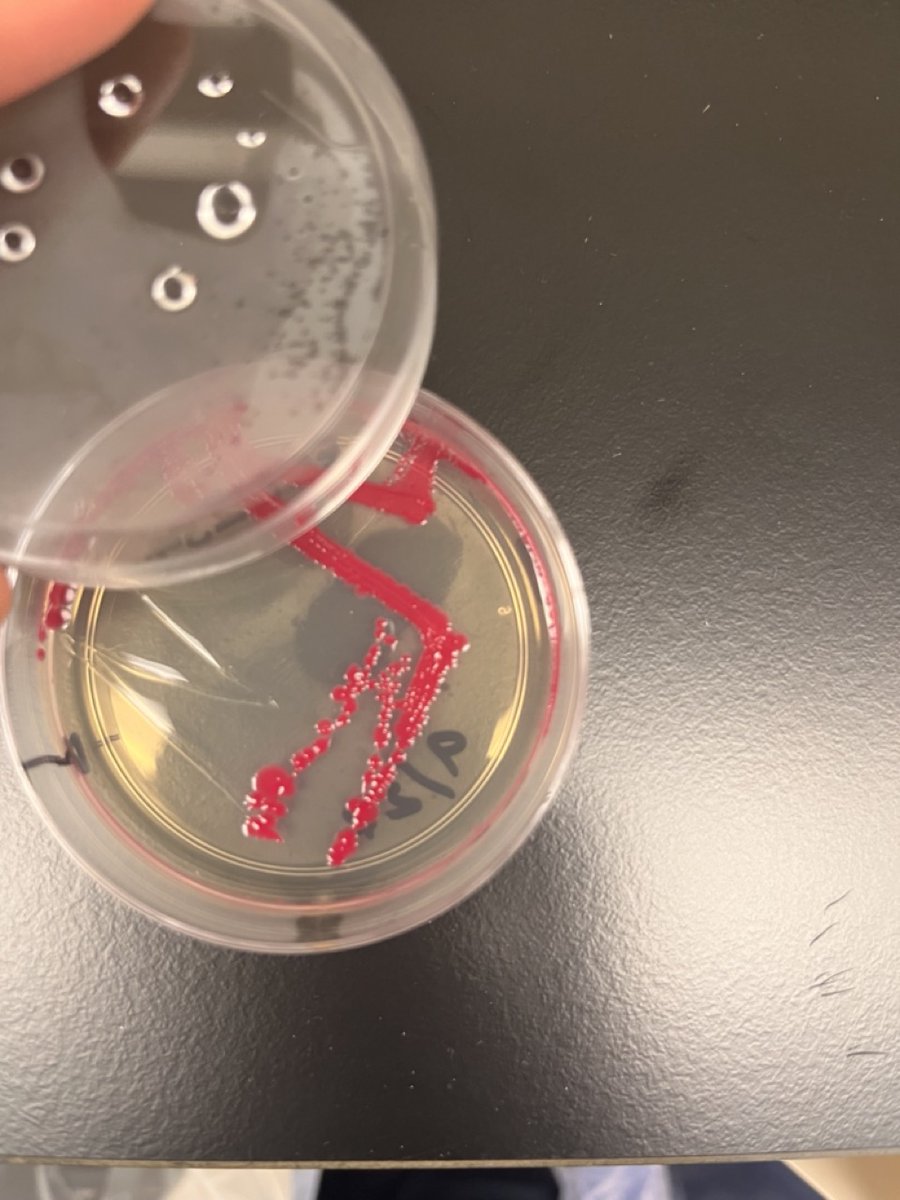
Caravel Bio tweet media

Caravel Bio retweetledi

We setup our first liquid handler today at @CaravelBio - A new Flex with the Nucleic Acid Extraction Module from @opentrons. For folks that have automated a lab before, what’s your favorite protocol to automate or automation resources?

English